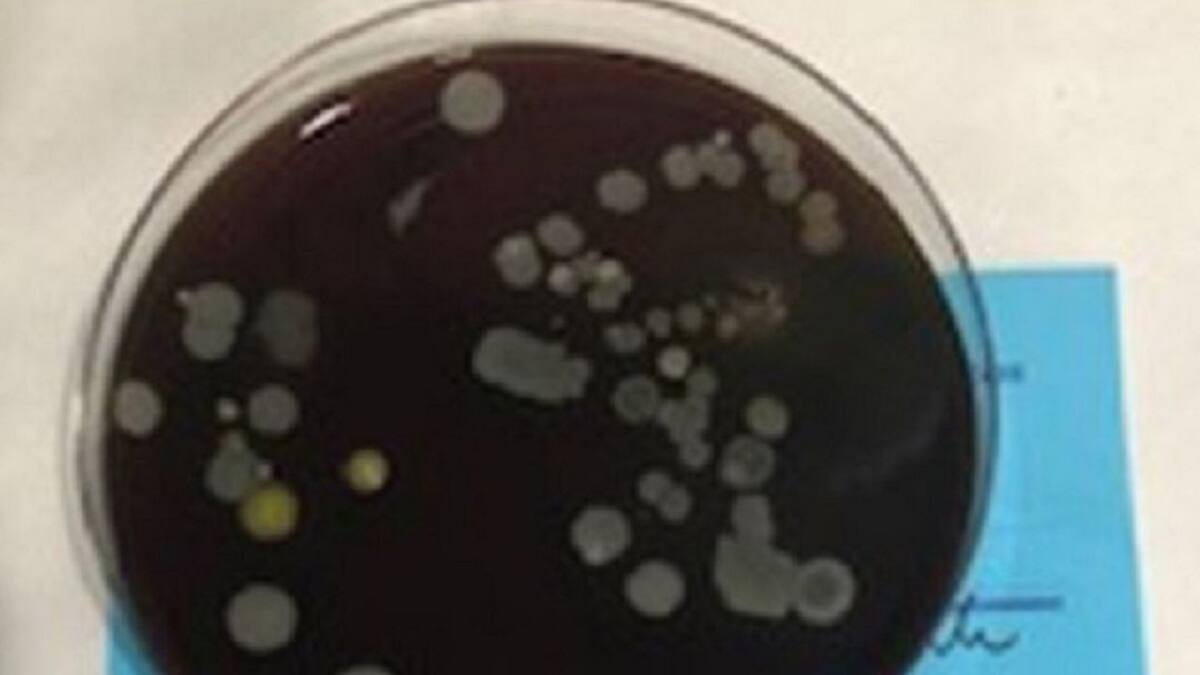
Un estudio revela que las mascarillas mal usadas pueden causar dermatitis

Javi Rodríguez
(La Palma, 1991) Periodista vinculado a la Cadena SER en Canarias desde el año 2009, apasionado de los fenómenos sociales e innato contador de historias. En 2021 recogí el Premio Ondas Nacional de Radio por la cobertura del volcán de La Palma, junto a los compañeros de informativos de la SER en Canarias.
05/02/2021
04/02/2021

Escuchar
00:06
Canarias registra su peor dato en dependencia y se sitúa a la cola de todo el país
El mes de enero arroja uno de los peores datos en materia de dependencia en la última década. Menos beneficiarios, menos prestaciones concedidas y menos resoluciones de grado en la Consejería de Derechos Sociales que dirige Podemos en el ejecutivo canario
04/02/2021 - 18:01
Javi Rodríguez
Santa Cruz de Tenerife
28/01/2021

Un año desde el primer caso de Covid-19 en España, detectado en La Gomera
Adelheid Schmid es la enfermera alemana que se enfundó en un equipo de protección individual para atender el primer caso de Covid-19 detectado en La Gomera hace exactamente un año
28/01/2021 - 15:18
Javi Rodríguez | Eric Pestano
Tenerife
25/01/2021
21/01/2021
20/01/2021

Indignación en el activismo canario por la decisión del Gobierno de no convocar subvenciones IRPF este año
Las entidades que conforman la Coordinadora de Acción Social de Canarias han presentado un recurso contra la Consejería de Derechos Sociales que dirige Noemí Santana y solicitan la convocatoria de las subvenciones en régimen de concurrencia competitiva
20/01/2021 - 21:39
Javi Rodríguez
Tenerife
19/01/2021
18/01/2021

Más de 7.000 personas esperan una pensión no contributiva en Canarias
"Con todo el hambre que estoy pasando aún tengo lucidez mental para denunciarlo", explica Marcial Cejas, que vive en Tiñor, un pequeño pueblo de Valverde en El Hierro donde espera desde hace dos años por la resolución de la pensión no contributiva del Gobierno de Canarias
18/01/2021 - 19:36
Javi Rodríguez
Tenerife
12/01/2021

"Si dejamos de cuidar tres días se cae la casa de mierda y nosotras de culpa"
"La culpa se vuelve contra nosotras cuando dejamos de hacer cosas. Decimos: si se me cae la casa de mierda pues que se caiga. Cuando de verdad la casa de verdad está sucia ya no puedes más y la limpias. Porque esos tres días te has estado sintiéndo horriblemente mal", explica María Martín Barranco
12/01/2021 - 19:03
Javi Rodríguez
Tenerife
08/01/2021

La ULL recibe una inyección económica que salvará la docencia e investigación
La transferencia por parte del Gobierno de Canarias es de dos millones de euros
08/01/2021 - 13:34
Ardiel Rodríguez | Javi Rodríguez
Tenerife
07/01/2021

Ni aislamiento ni mascarillas: así funcionó en pleno brote la mayor residencia de Canarias
"A Dios hay que recurrir para rezar, pero no para establecer los mecanismos de transmisión de un virus. Eso lo hace la ciencia", explica Natacha Sujanani, la responsable de frenar el brote de coronavirus que ha causado más de veinte muertos en la residencia católica Hogar Santa Rita II, intervenida por Salud Pública
07/01/2021 - 19:18
Javi Rodríguez
Tenerife
04/01/2021
22/12/2020

La imponente imagen de Júpiter y Saturno juntos desde El Teide
El fotógrafo palmero aficionado a la astrofísica Jacinto Hernández ha capturado el encuentro entre los dos gigantes planetarios desde las Cañadas de El Teide, uno de los puntos más altos de España
22/12/2020 - 12:12
Javi Rodríguez
Tenerife